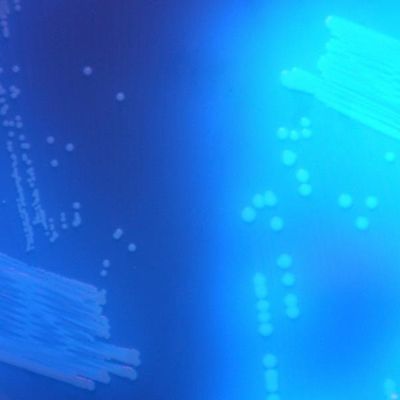

Chromagar - C. Difficile
Clostridioides difficile is the leading cause of nosocomial infectious diarrhea in adults.These infections occur mostly in patients who have both medical care and antibiotic treatment.
The symptoms of C. difficile infection are fever, abdominal cramps and severe diarrhea leading to death. In the United States, nearly 250,000 people each year develop C. difficile infections with at least 14 000 deaths (CDC estimate, 2013). Due to the emergence of highly toxigenic C. difficile strains, these infections have become more frequent and more difficult to treat in the last years.
Although PCR has become the leading C. difficile detection technique, culture is essential for strain typing and antimicrobial susceptibility testing. CHROMagar™ C.difficile is a fluorogenic culture medium, extremely sensitive and selective, especially designed to simplify and speed up (24 h) the culture of C. difficile.

